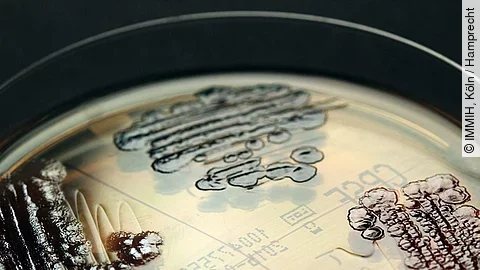
Multiresistente Keime Multiresistente Keime

Resistenzen ausgebildet
Nicht immer ist eine Lösung so einfach wie im Falle des Klebsiella-oxytoca-Bakteriums, der selbst von Medizinern als Sonderfall bezeichnet wurde. Der vermehrte Einsatz von Breitspektrum-Antibiotika steht mit der Zunahme von multiresistenten Erregern in direkter Wechselbeziehung. Zu häufig verordneten Ärzte in der Vergangenheit Antibiotika, obwohl die Patienten sie gar nicht brauchten. Denn: Viele Erkältungskrankheiten etwa werden von Viren ausgelöst, gegen die Antibiotika unwirksam sind. Zunehmend verkompliziert sich demzufolge auch die antibiotische Therapie von Hospitalinfektionen, wobei häufig mehr als ein Medikament gegeben werden muss. Aber auch Patienten haben es selbst in der Hand: Wer das verordnete Antibiotikum zu kurz oder falsch einnimmt, verbessert für Bakterien die Chance, sich an die Wirkstoffe so anzupassen, dass diese die Erreger nicht mehr abtöten können. Bakterien können sich widrigen Bedingungen anpassen, indem sie sich verändern. Die Mutation schützt sie dann vor der zerstörerischen Wirkung von Antibiotika. Resistente Keime sind also ein weltweit wachsendes Problem.
Europaweite Verbreitungswege
Wie sich die Bakterien genau verbreiten, beschreibt eine internationale Forschungsgruppe um Wissenschaftler des Uniklinikums Freiburg in einer jüngst erschienenen Studie. Demnach leisten Krankenhäuser und die Verlegung von Patienten den entscheidenden Beitrag zur Verbreitung der Erreger. Die Verbreitungswege ließen sich anhand detaillierter genetischer Analysen nachvollziehen. Dabei wurden ein halbes Jahr lang in 455 Krankenhäusern in 36 europäischen Ländern Proben gesammelt: „Unsere Beobachtungen sprechen dafür, dass sich extrem resistente Bakterien vor allem innerhalb einzelner Krankenhäuser sowie bei der Verlegung von Patienten zwischen geografisch naheliegenden Krankenhäusern verbreiten“, erläutert Professor Hajo Grundmann, Leiter des Instituts für Infektionsprävention des Freiburger Uniklinikums. Das A und O sei jedoch eine gute Krankenhaushygiene. Daher sei es auch extrem wichtig, Patienten bei der Aufnahme nach früheren Krankenhausaufenthalten im In- und Ausland zu befragen.
Neue Waffe gegen resistente Keime?
Neben der Hygiene könnte auch Teixobactin das Kräfteverhältnisse wieder zu Gunsten der Mediziner zurechtrücken. Es setzt – wie das artverwandte Penicillin – an der Bakterienzellwand an, so dass sich der Erreger nicht mehr teilen kann. „Ohne Zellwand sind die Bakterien nicht lebensfähig“, erklärt Dr. Tanja Schneider von der Uniklinik Bonn. Forscher sehen daher in diesem Wirkstoff eine vielversprechende Leitsubstanz für neue Antibiotika.
Das Team um Schneider forscht – zusammen mit Tübinger Kollegen – zu Multiresistenzen durch Antibiotika und will neue, wirksame Substanzen entwickeln. Für die Professorin für Pharmazeutische Mikrobiologie gehören das zu häufige Einnehmen und mitunter zu frühzeitige Absetzen von Antibiotika ganz klar zu den Ursachen der zunehmenden Wirkungslosigkeit der einstigen Wundermittel: „Die Resistenzen entwickeln sich deutlich schneller als neue Wirkstoffe auf den Markt kommen.“ Schneider erklärt weiter: „Das Teixobactin ist ein ganz außergewöhnliches Antibiotikum, denn wir konnten es im Labor bisher nicht schaffen, durch wiederholte und immer mehr Gabe der Substanz Resistenzen zu erzeugen“. Das ruft verhaltenen Optimismus beim Team vor. Dennoch sei auch mit der neuen Substanz das Resistenz-Problem nicht auf Dauer gelöst. „Es ist immer nur eine Frage der Zeit, bis die Erreger mutieren und ihnen auch die neuen Medikamente nichts mehr anhaben können“, gibt Schneider zu bedenken. „Das ist ein ewiges Wettrüsten.“

Derzeit sind noch keine Kommentare vorhanden. Schreiben Sie den ersten Kommentar!
Jetzt einloggen